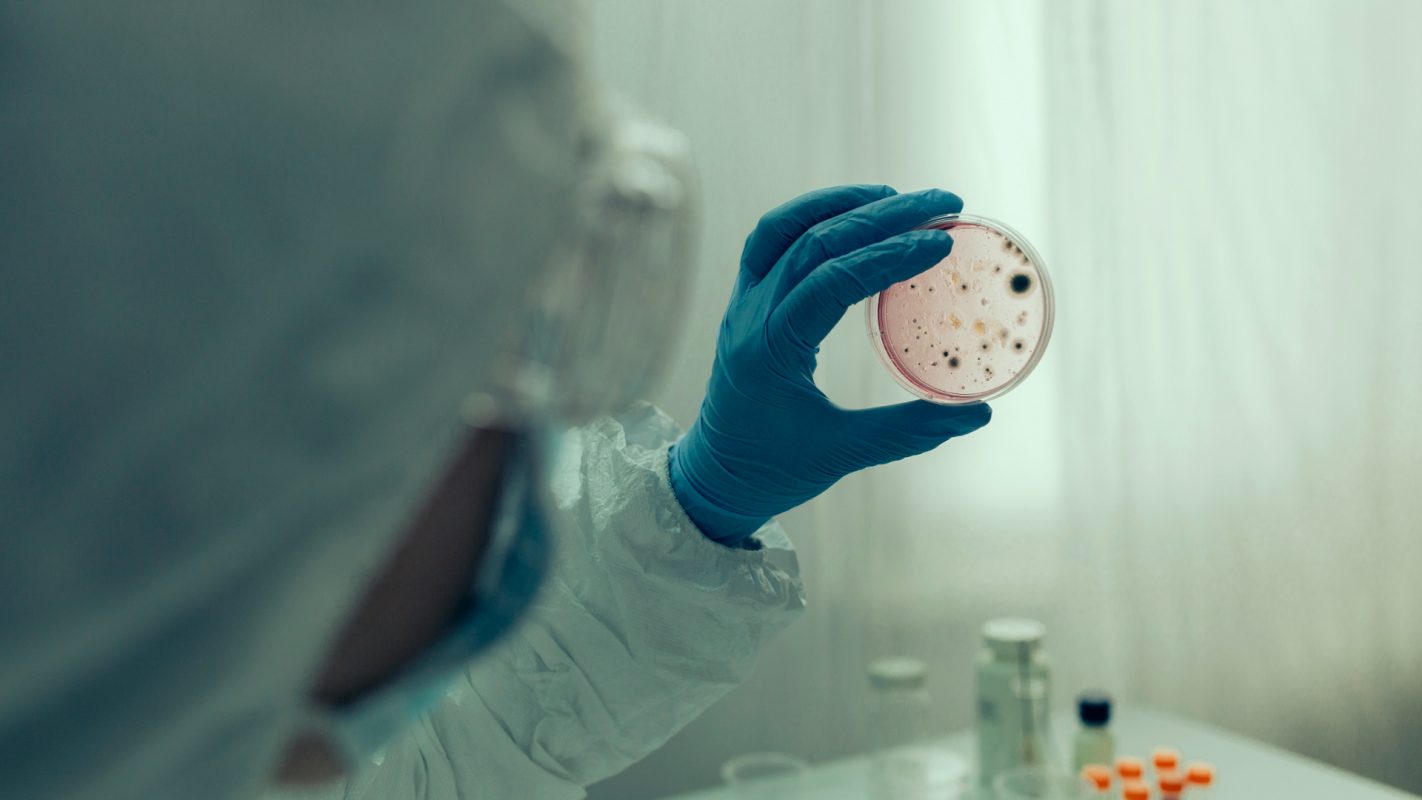

A mediados de febrero, la Organización Mundial de la Salud (OMS) lanzó una preocupante alerta para Europa al detectar en Ghana de nueve casos de fiebre hemorrágica de Marburgo, un virus muy similar al virus de Ébola. De entre todos ellos, siete pacientes murieron y, actualmente, hay alrededor de una veintena de posibles fallecidos por esta enfermedad, según la institución sanitaria.
Desde la propia OMS ya advierten de que la letalidad de esta enfermedad es de hasta el 88%. Ahora bien, ¿qué es realmente el virus Marburgo? ¿Cómo se contagia? Estos son algunos de los datos para obtener más información de esta enfermedad que ya se ha saldado a su primera víctima mortal en Tanzania, al este de África.
El virus Marburgo, conocido antiguamente como enfermedad por el virus de Marburgo (EVM) se identificó por primera vez en 1967 en el momento en el que detectaron casos en Marburgo y Frankfurt, en Alemania, así como en Belgrado (Serbia).
Tal y como explican las autoridades sanitarias, la detección de los primeros casos se asoció a los laboratorios, concretamente a aquellos en los que se trabajaba con monos verdes africanos, aunque en 2008 tuvieron noticias de otros dos positivos que eran viajeros que habían visitado una cueva de murciélagos en Uganda.
En palabras de la doctora Leana Wen, médica de urgencias y profesora en la Escuela de Salud Pública del Instituto Milken de la Universidad George Washington, se trata de una enfermedad causada por el mismo virus que provoca el Ébola. Asimismo, avisa de que puede afectar a humanos y a primates, ya que se trata de una enfermedad zoonótica; es decir, que es una transmisión que pasa de animales a seres humanos.
Wen señala, a su vez, que identificaron los murciélagos frugívoros como los portadores del virus.
Al igual que ocurre con el Ébola, esta enfermedad provoca una «fiebre hemorrágica severa» —sangrado por varios orificios— que puede afectar a diversos sistemas de órganos e, incluso, puede derivar en un sangrado; como explica Wen a la CNN. Pero estos son los únicos síntomas del Marburgo y puntualiza que se trata de una enfermedad «extremadamente mortal» y «altamente contagiosa».
«Con brotes anteriores, las tasas de letalidad oscilaron entre el 24 % y el 88 %, con una tasa de letalidad promedio de alrededor del 50%. Eso significa que aproximadamente la mitad de las personas que contraen la enfermedad morirán a causa de ella», destaca. Estos son algunos de los síntomas más comunes del virus:
La sangre provocada por la fiebre hemorrágica severa puede aparecer por los ojos, las encías, la nariz, los vómitos, las heces o la orina. De hecho, este sangrado puede llegar a provocar incluso la muerte. Estos efectos del virus de Marburgo pueden aparecer entre los dos primeros días desde el contagio hasta las dos semanas.
El aspecto que pueden presentar las personas contagiadas es, en palabras de la OMS, de «aspecto fantasma» (hundimiento de los ojos, la inexpresividad facial).
Al principio, debido a los casos confirmados, la OMS identificó el foco de transmisión de este virus en las minas o cuevas habitadas por colonias de murciélagos Rousettus. Pero el contagio entre personas se produce por contacto directo con la piel afectada con las mucosas de la sangre, secreciones u otros líquidos del cuerpo de los pacientes. También se transmiten a través de superficies u objetos contaminados, incluyendo la ropa.
«También se puede dar esta transmisión en las ceremonias funerarias en que los dolientes tienen contacto directo con el cuerpo del difunto», destacan desde a OMS.
MÁS SOBRE:
© Sociedad Española de Radiodifusión, S.L.U. 2026. Todos los derechos reservados
© Quedan reservados todos los derechos tanto sobre programas radiofónicos y las obras y prestaciones que formen parte de ellos, como sobre los contenidos publicados en esta página web. Sociedad Española de Radiodifusión SLU ejerce la oposición expresa frente al uso de sus obras y prestaciones en la elaboración de revistas de prensa prevista en el artículo 32.1 del TRLPI. Sociedad Española de Radiodifusión SLU realiza la reserva expresa frente la reproducción, distribución y comunicación pública de sus trabajos y artículos sobre temas de actualidad prevista en el artículo 33.1 del TRLPI, asimismo, también realiza una reserva expresa de las reproducciones y usos de las obras y otras prestaciones accesibles desde este sitio web a medios de lectura mecánica u otros medios que resulten adecuados a tal fin de conformidad con el artículo 67.3 del Real Decreto - ley 24/2021, de 2 de noviembre, así como frente a cualquier utilización de sus contenidos por tecnologías de inteligencia artificial, sea cual sea su naturaleza y finalidad.